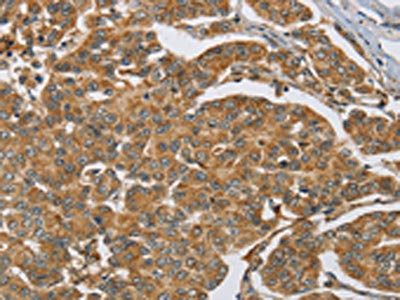

MAPK6 Antibody
-
中文名稱:MAPK6兔多克隆抗體
-
貨號:CSB-PA243230
-
規格:¥1100
-
圖片:
-
The image on the left is immunohistochemistry of paraffin-embedded Human cervical cancer tissue using CSB-PA243230(MAPK6 Antibody) at dilution 1/40, on the right is treated with synthetic peptide. (Original magnification: ×200)
-
The image on the left is immunohistochemistry of paraffin-embedded Human breast cancer tissue using CSB-PA243230(MAPK6 Antibody) at dilution 1/40, on the right is treated with synthetic peptide. (Original magnification: ×200)
-
-
其他:
產品詳情
-
Uniprot No.:
-
基因名:
-
別名:ERK-3 antibody; ERK3 antibody; Extracellular signal regulated kinase 3 antibody; Extracellular signal regulated kinase p97 antibody; Extracellular signal-regulated kinase 3 antibody; HsT17250 antibody; MAP kinase 6 antibody; MAP kinase isoform p97 antibody; MAPK 6 antibody; MAPK6 antibody; Mitogen activated protein kinase 6 antibody; Mitogen-activated protein kinase 6 antibody; MK06_HUMAN antibody; p97 MAPK antibody; p97-MAPK antibody; PRKM6 antibody; Protein kinase mitogen activated 5 antibody; Protein kinase mitogen activated 6 antibody
-
宿主:Rabbit
-
反應種屬:Human,Mouse,Rat
-
免疫原:Synthetic peptide of Human MAPK6
-
免疫原種屬:Homo sapiens (Human)
-
標記方式:Non-conjugated
-
抗體亞型:IgG
-
純化方式:Antigen affinity purification
-
濃度:It differs from different batches. Please contact us to confirm it.
-
保存緩沖液:-20°C, pH7.4 PBS, 0.05% NaN3, 40% Glycerol
-
產品提供形式:Liquid
-
應用范圍:ELISA,IHC
-
推薦稀釋比:
Application Recommended Dilution ELISA 1:2000-1:5000 IHC 1:50-1:200 -
Protocols:
-
儲存條件:Upon receipt, store at -20°C or -80°C. Avoid repeated freeze.
-
貨期:Basically, we can dispatch the products out in 1-3 working days after receiving your orders. Delivery time maybe differs from different purchasing way or location, please kindly consult your local distributors for specific delivery time.
-
用途:For Research Use Only. Not for use in diagnostic or therapeutic procedures.
相關產品
靶點詳情
-
功能:Atypical MAPK protein. Phosphorylates microtubule-associated protein 2 (MAP2) and MAPKAPK5. The precise role of the complex formed with MAPKAPK5 is still unclear, but the complex follows a complex set of phosphorylation events: upon interaction with atypical MAPKAPK5, ERK3/MAPK6 is phosphorylated at Ser-189 and then mediates phosphorylation and activation of MAPKAPK5, which in turn phosphorylates ERK3/MAPK6. May promote entry in the cell cycle.
-
基因功能參考文獻:
- Metformin sensitizes arsenic trioxide to suppress intrahepatic cholangiocarcinoma via the regulation of AMPK/p38 MAPK-ERK3/mTORC1 pathways. ERK3 is a newfound potential prognostic predictor and a tumor suppressor in ICC. PMID: 28241849
- Study revealed a post-translational regulation of TDP2 activity and discovered a new role of ERK3 in increasing cancer cells' DNA damage response and chemoresistance to Top2 inhibitors. PMID: 26701725
- MAPK6 could rescue the cell growth induced by miR499a and HBV PMID: 25340781
- ERK3 regulates endothelial cell migration, proliferation and tube formation by upregulating SRC-3/SP-1-mediated VEGFR2 expression. PMID: 24585635
- These findings further expand distinct roles of cyclin D3 and suggest the potential activity of ERK3 in cell proliferation. PMID: 16360641
- Cdc14A forms a stable complex with atypical mitogen-activated protein kinase Erk3 in human cells independent of its intrinsic phosphatase activity but mediated by its regulatory C-terminal domain. PMID: 18235225
- identify the Erk3 protein as a novel class I Pak substrate and further suggest a role for Pak kinase activity in atypical MAPK signaling. PMID: 21317288
- A previously unknown role for ERK3 in promoting lung cancer cell invasiveness by phosphorylating SRC-3 and regulating SRC-3 proinvasive activity by site-specific phosphorylation. PMID: 22505454
- ERK3 biological activity is regulated by its cellular abundance through the control of protein stability PMID: 12808096
- Data show that extracellular signal-regulated kinase 3 (ERK3) is conjugated to ubiquitin via its free NH(2) terminus, and that N-terminal tags stabilize expression of p21 but not that of substrates ubiquitinated on internal lysine residues. PMID: 15226418
- Extracellular signal-regulated kinase-3 (ERK3/MAPK6) is highly expressed in response to BRAF signaling. PMID: 16964379
顯示更多
收起更多
-
亞細胞定位:Cytoplasm. Nucleus.
-
蛋白家族:Protein kinase superfamily, CMGC Ser/Thr protein kinase family, MAP kinase subfamily
-
組織特異性:Highest expression in the skeletal muscle, followed by the brain. Also found in heart, placenta, lung, liver, pancreas, kidney and skin fibroblasts.
-
數據庫鏈接:
Most popular with customers
-
YWHAB Recombinant Monoclonal Antibody
Applications: ELISA, WB, IHC, IF, FC
Species Reactivity: Human, Mouse, Rat
-
Phospho-YAP1 (S127) Recombinant Monoclonal Antibody
Applications: ELISA, WB, IHC
Species Reactivity: Human
-
-
-
-
-
-